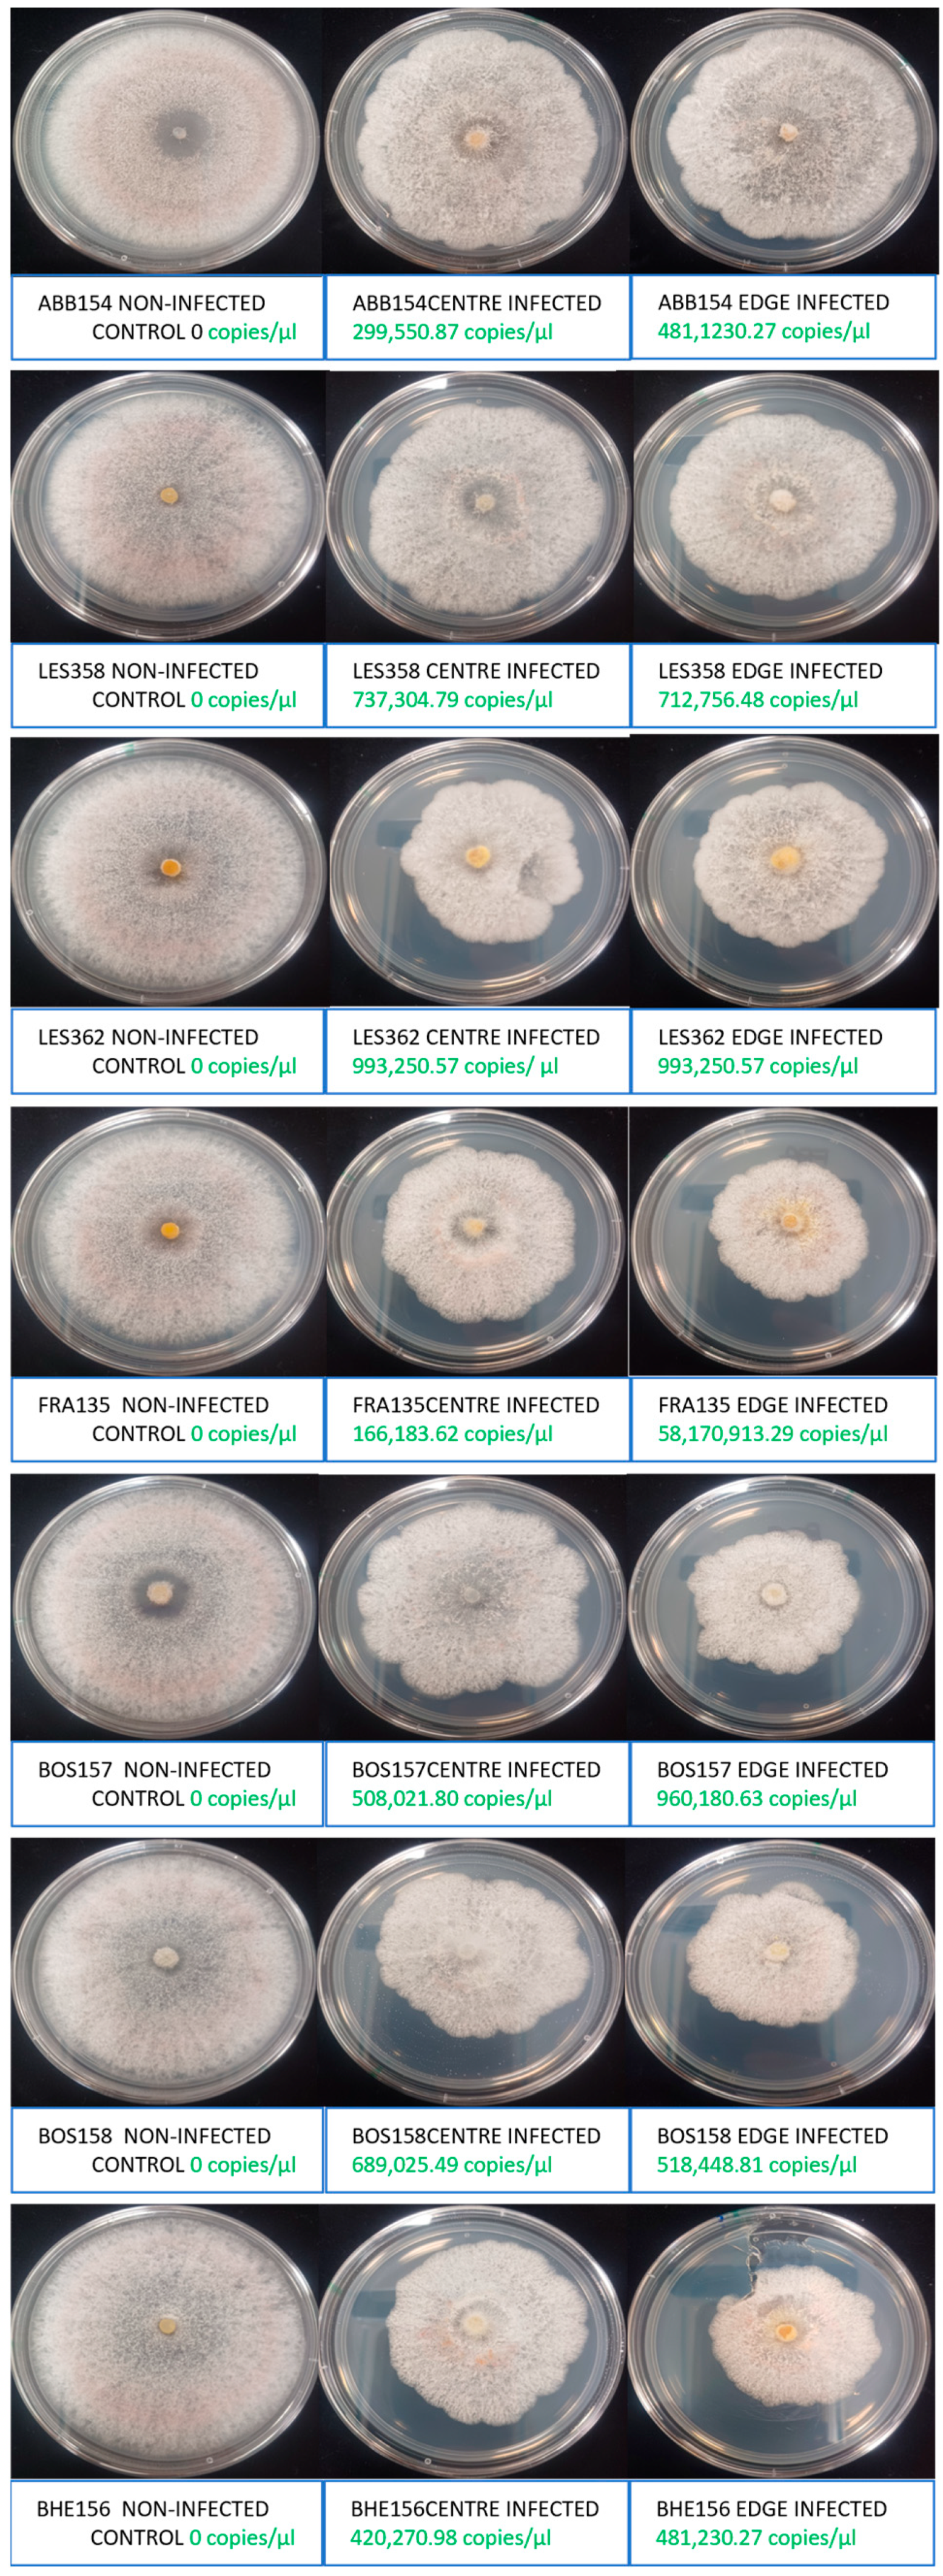
Ijms 25 12023 g001

Transmission of Cryphonectria Hypovirus 1 (CHV1) to Cryphonectria radicalis and In Vitro and In Vivo Testing of Its Potential for Use as Biocontrol Against C. parasitica
Abstract
1. Introduction
2. Results
2.1. Isolates
2.2. Transmissions
2.3. Colony Colour, Area, Colony Parts, Conidiation and Conidia Transmission
2.4. Competition
2.5. Primary Capture
2.6. Secondary Capture
2.7. Relative Virulence
2.8. Biocontrol Potential
3. Discussion
4. Materials and Methods
4.1. Sampling, Isolation and Preservation
4.2. Direct and Reverse Transmissions of the CHV1 Virus
4.3. Pigmentation, Spatial Differences in Viral Concentration Within Colony, Growth Rate, Sporulation Rate, and Vertical Transmission by Conidia
4.4. In Vitro Differential Competition
4.5. Primary Resource Capture
4.6. Secondary Resource Capture
4.7. In Planta Experiments
5. Conclusions
Supplementary Materials
Author Contributions
Funding
Institutional Review Board Statement
Informed Consent Statement
Data Availability Statement
Acknowledgments
Conflicts of Interest
References
- Anagnostakis, S.L. Chestnut blight: The classical problem of an introduced pathogen. Mycologia 1987, 79, 23–37. [Google Scholar] [CrossRef]
- Biraghi, A. Il cancro del castagno causato da Endothia parasitica. Ital. Agric. 1946, 7, 406. [Google Scholar]
- EPPO. Cryphonectria parasitica. Bull. EPPO 2005, 35, 295–298. [Google Scholar] [CrossRef]
- Hunter, G.; Wylder, B.; Jones, B.; Webber, J.F. First finding of Cryphonectria parasitica causing chestnut blight on Castanea sativa trees in Britain. New Dis. Rep. 2013, 27, 1. [Google Scholar] [CrossRef]
- Forestry Commission. Sweet Chestnut Blight (Cryphonectria parasitica). 2019. Available online: https://www.forestresearch.gov.uk/tools-and-resources/pest-and-disease-resources/sweet-chestnut-blight-cryphonectria-parasitica/ (accessed on 1 June 2024).
- Pérez-Sierra, A.; Romon-Ochoa, P.; Gorton, C.; Lewis, A.; Rees, H.; van der Linde, S.; Webber, J. High vegetative compatibility diversity of Cryphonectria parasitica infecting sweet chestnut (Castanea sativa) in Britain indicates multiple pathogen introductions. Plant Pathol. 2019, 68, 727–737. [Google Scholar] [CrossRef]
- Romon-Ochoa, P.; Kranjec Orlovic, J.; Gorton, C.; Lewis, A.; van der Linde, S.; Pérez-Sierra, A. New detections of chestnut blight in Britain during 2019–2020 reveal high Cryphonectria parasitica diversity and limited spread of the disease. Plant Pathol. 2021, 71, 793–804. [Google Scholar] [CrossRef]
- Romon-Ochoa, P.; Forster, J.; Chitty, R.; Gorton, C.; Lewis, A.; Eacock, A.; Kupper, Q.; Rigling, D.; Pérez-Sierra, A. Canker development and biocontrol potential of CHV1 infected English isolates of Cryphonectria parasitica is dependent on the virus concentration and the compatibility of the fungal inoculums. Viruses 2022, 14, 2678. [Google Scholar] [CrossRef]
- Romon-Ochoa, P.; Smith, O.; Lewis, A.; Kupper, Q.; Shamsi, W.; Rigling, D.; Pérez-Sierra, A.; Ward, L. Temperature effects on the Cryphonectria hypovirus 1 accumulation and recovery within its fungal host, the chestnut blight pathogen Cryphonectria parasitica. Viruses 2023, 15, 1260. [Google Scholar] [CrossRef]
- Romon-Ochoa, P.; Samal, P.; Gorton, C.; Lewis, A.; Chitty, R.; Eacock, A.; Krzywinska, E.; Crampton, M.; Pérez-Sierra, A.; Biddle, M.; et al. Cryphonectria parasitica detections in England, Jersey, and Guernsey during 2020–2023 reveal newly affected areas and infections by the CHV1 mycovirus. J. Fungi 2023, 9, 1036. [Google Scholar] [CrossRef]
- Choi, G.H.; Nuss, D.L. Hypovirulence of chestnut blight fungus conferred by an infectious viral cDNA. Science 1992, 257, 800–803. [Google Scholar] [CrossRef]
- Hillman, B.I.; Suzuki, N. Viruses of the chestnut blight fungus, Cryphonectria parasitica. Adv. Virus Res. 2004, 63, 423–472. [Google Scholar] [PubMed]
- Fahima, T.; Kazmierczak, P.; Hansen, D.R.; Pfeiffer, P.; van Alfen, N.K. Membrane-associated replication of an unencapsidated double-strand RNA of the fungus, Cryphonectria parasitica. Virology 1993, 195, 81–89. [Google Scholar] [CrossRef] [PubMed]
- Rigling, D.; Prospero, S. Cryphonectria parasitica, the causal agent of chestnut blight: Invasion history, population biology and disease control. Mol. Plant Path. 2018, 19, 7–20. [Google Scholar] [CrossRef] [PubMed]
- Hoegger, P.J.; Rigling, D.; Holdenrieder, O.; Heiniger, U. Cryphonectria radicalis: Rediscovery of a lost fungus. Mycologia 2002, 94, 105–115. [Google Scholar] [CrossRef] [PubMed]
- Chandelier, A.; Massot, M.; Fabreguettes, O. Early detection of Cryphonectria parasitica by real-time PCR. Eur. J. Plant Pathol. 2019, 153, 135–152. [Google Scholar] [CrossRef]
- Liu, Y.-C.; Dynek, J.N.; Hillman, B.I.; Milgroom, M.G. Diversity of viruses in Cryphonectria parasitica and C. nitschkei in Japan and China, and partial characterization of a new chrysovirus species. Mycol. Res. 2007, 111, 433–442. [Google Scholar] [CrossRef]
- Peever, T.L.; Liu, Y.-C.; Wang, K.; Hillman, B.I.; Foglia, R.; Milgroom, M.G. Incidence and diversity of double-stranded RNAs occurring in the chestnut blight fungus, Cryphonectria parasitica, in China and Japan. Phytopathology 1998, 88, 811–817. [Google Scholar] [CrossRef]
- Park, S.-M.; Kim, J.-M.; Chung, H.-J.; Lim, J.-Y.; Kwon, B.-R.; Lim, J.-G.; Kim, J.-A.; Kim, M.-J.; Cha, B.-J.; Lee, S.-H.; et al. Occurrence of diverse dsRNA in a Korean population of the chestnut blight fungus Cryphonectria parasitica. Phytopathology 2008, 112, 1220–1226. [Google Scholar] [CrossRef]
- Gobbin, D.; Hoegger, P.J.; Heiniger, U.; Rigling, D. Sequence variation and evolution of Cryphonectria hypovirus 1 (CHV-1) in Europe. Virus Res. 2003, 97, 39–46. [Google Scholar] [CrossRef]
- Rigling, D.; Borst, N.; Cornejo, C.; Supatashvili, A.; Prospero, S. Genetic and phenotypic characterization of Cryphonectria hypovirus 1 from Eurasian Georgia. Viruses 2018, 10, 687. [Google Scholar] [CrossRef]
- Bryner, S.F.; Rigling, D. Temperature-dependent genotype-by-genotype interaction between a pathogenic fungus and its hyperparasitic virus. Am. Nat. 2011, 177, 65–74. [Google Scholar] [CrossRef] [PubMed]
- Cornejo, C.; Sever, B.; Kupper, Q.; Prospero, S.; Rigling, D. A multiplexed genotyping assay to determine vegetative incompatibility and mating type in Cryphonectria parasitica. Eur. J. Plant Pathol. 2019, 155, 81–91. [Google Scholar] [CrossRef]
- Liu, Y.C.; Linder-Basso, D.; Hillman, B.I.; Kaneko, S.; Milgroom, M.G. Evidence of interspecies transmission of viruses in natural populations of filamentous fungi in the genus Cryphonectria. Mol. Ecol. 2013, 12, 1619–1628. [Google Scholar] [CrossRef] [PubMed]
- Kotta-Loizou, I.; Coutts, R.H.A. Studies on the virome of the entomopathogenic fungus Beauveria bassiana reveal novel dsRNA elements and mild hypervirulence. PLoS Pathog. 2017, 13, e1006183. [Google Scholar] [CrossRef]
- Zhai, L.; Zhang, M.; Hong, N.; Xiao, F.; Fu, M.; Xiang, J.; Wang, G. Identification and characterization of a novel hepta-segmented dsRNA virus from the phytopathogenic fungus Colletotrichum fructicola. Front. Microbiol. 2018, 9, 754. [Google Scholar] [CrossRef]
- Cornejo, C.; Hisano, S.; Braganza, H.; Suzuki, N.; Rigling, D. A new double-stranded RNA mycovirus in Cryphonectria naterciae is able to cross the species barrier and is deleterious to a new host. J. Fungi 2021, 7, 861. [Google Scholar] [CrossRef]
- Wang, J.; Ni, Y.; Liu, X.; Zhao, H.; Xiao, Y.; Xiao, X.; Li, S.; Liu, H. Divergent RNA viruses in Macrophomina phaseolina exhibit potential as virocontrol agents. Virus Evol. 2021, 7, veaa095. [Google Scholar] [CrossRef]
- Mahillon, M.; Decroës, A.; Caulier, S.; Tiendrebeogo, A.; Legrève, A.; Bragard, C. Genomic and biological characterization of a novel partitivirus infecting Fusarium equiseti. Virus Res. 2021, 297, 198386. [Google Scholar] [CrossRef]
- Chen, B.; Choi, G.H.; Nuss, D.L. Attenuation of fungal virulence by synthetic infectious hypovirus transcripts. Science 1994, 264, 1762–1764. [Google Scholar] [CrossRef]
- Romon, P.; Troya, M.; Fernandez de Gamarra, M.E.; Eguzkitza, A.; Iturrondobeitia, J.C.; Goldarazena, A. Fungal communities associated with pitch canker disease of Pinus radiata caused by Fusarium circinatum in northern Spain: Association with insects and pathogen-saprophytes antagonistic interactions. Can. J. Plant Pathol. 2008, 30, 241–253. [Google Scholar] [CrossRef]
- Klepzig, K.D.; Wilkens, R.T. Competitive interactions among symbiotic fungi of the southern pine beetle. Appl. Environ. Microbiol. 1997, 63, 621–627. [Google Scholar] [CrossRef] [PubMed]

| # | Host | Collection ID | Year | CHV1 Detection (ng/µL) | Culture Preserved | Reference | County | GenBank Accession Number |
|---|---|---|---|---|---|---|---|---|
| C. parasitica | ||||||||
| 1 | Castanea sativa | FTC687 | 2020 | 415.95 | Yes | [8], this study | London | |
| 2 | C. sativa | WAR706 | 2021 | 428.41 | Yes | [8], this study | Devon | |
| 3 | C. sativa | HYD574 | 2019 | 588.52 | Yes | [8], this study | London | |
| C. radicalis | ||||||||
| 1 | C. sativa | CHI71 | 2017 | No | - | London | ||
| 2 | C. sativa | HAY113 | 2017 | No | - | Devon | ||
| 3 | C. sativa | LES129a | 2017 | No | - | London | ||
| 4 | C. sativa | BLA134 | 2017 | No | - | London | ||
| 5 | C. sativa | FRA135 | 2017 | Yes | This study | London | PQ373832 | |
| 6 | C. sativa | BOS143 | 2017 | No | - | London | ||
| 7 | C. sativa | BOS144 | 2017 | No | - | London | ||
| 8 | C. sativa | ABB154 | 2017 | Yes | This study | London | PQ373833 | |
| 9 | C. sativa | BHE156 | 2017 | Yes | This study | London | PQ373834 | |
| 10 | C. sativa | BOS157 | 2017 | Yes | This study | London | PQ373835 | |
| 11 | C. sativa | BOS158 | 2017 | Yes | This study | London | PQ373836 | |
| 12 | C. sativa | BOS159 | 2017 | Yes | - | London | ||
| 13 | C. sativa | LES358 | 2018 | Yes | This study | London | PQ373837 | |
| 14 | C. sativa | LES362 | 2018 | Yes | This study | London | PQ373838 | |
| 15 | C. sativa | LES412 | 2018 | No | - | London | ||
| 16 | C. sativa | LES415 | 2018 | No | - | London | ||
| 17 | C. sativa | TAD429 | 2019 | No | - | Surrey | ||
| 18 | C. sativa | LES450 | 2019 | No | - | London | ||
| 19 | C. sativa | DEN498 | 2019 | No | - | London | ||
| 20 | C. sativa | JAC565 | 2019 | No | - | London | ||
| 21 | C. sativa | JAC566 | 2019 | 8.8 | Yes | [7] | London | MT256128 |
| 22 | C. sativa | KEN590 | 2020 | 19.6 | Yes | [7] | London | MT256129 |
| 23 | C. sativa | WCP609 | 2020 | No | - | London | ||
| 24 | C. sativa | ACO701 | 2021 | No | - | Somerset | ||
| 25 | C. sativa | ACO703 | 2021 | No | - | Somerset | ||
| 26 | C. sativa | KEN719 | 2021 | No | - | London | ||
| 27 | C. sativa | POWP733 | 2021 | No | - | Devon | ||
| 28 | C. sativa | POWP734 | 2021 | No | - | Devon | ||
| 29 | C. sativa | WATL739 | 2021 | No | - | London |
| Infected C. parasitica Isolate | |||
|---|---|---|---|
| C. radicalis | FTC687 EU10 | WAR706 EU9 | HYD574 EU2 |
| ABB154 | - 0 | 24.33 333,833.11 copies/µL * | - 0 |
| LES358 | - 0 | - 0 | - 0 |
| LES362 | - 0 | - 0 | - 0 |
| FRA135 | - 0 | - 0 | - 0 |
| BOS157 | - 0 | - 0 | - 0 |
| BOS158 | - 0 | - 0 | - 0 |
| BHE156 | - 0 | - 0 | - 0 |
| HAY113 | - 0 | - 0 | - 0 |
| BOS159 | - 0 | - 0 | - 0 |
| Infected C. radicalis | |
|---|---|
| C. radicalis | ABB154 |
| LES358 | 25.30 173,075.38 * |
| LES362 | 23.94 434,745.69 |
| FRA135 | 25.04 206,398.18 |
| BOS157 | 23.54 570,009.84 |
| BOS158 | 23.05 794,328.23 |
| BHE156 | 24.41 316,227.76 |
| Infected C. radicalis Isolate | |||||||
|---|---|---|---|---|---|---|---|
| C. parasitica VCG | ABB154 | LES358 | LES362 | FRA135 | BOS157 | BOS158 | BHE156 |
| EU1 | |||||||
| EU2 | |||||||
| EU3 | |||||||
| EU4 | |||||||
| EU5 | |||||||
| EU6 | |||||||
| EU7 | |||||||
| EU8 | |||||||
| EU9 | 35 242.82 copies/µL * | ||||||
| EU10 | |||||||
| EU11 | |||||||
| EU12 | |||||||
| EU13 | |||||||
| EU14 | |||||||
| EU15 | |||||||
| EU16 | 24.24 354,813.38 copies/µL | 33.47 684.37 copies/µL | 23.88 452,774.91 copies/µL | 22.98 832,891.12 copies/µL | 32.73 1129.64 copies/µL | 24.7 259,839.92 copies/µL | 34.6 318.37 copies/µL |
| EU17 | |||||||
| EU18 | |||||||
| EU19 | |||||||
| EU20 | 30.11 6660.84 copies/µL | ||||||
| EU21 | |||||||
| EU22 | |||||||
| EU23 | |||||||
| EU24 | |||||||
| EU25 | |||||||
| EU26 | |||||||
| EU27 | |||||||
| EU28 | |||||||
| EU29 | |||||||
| EU30 | |||||||
| EU31 | |||||||
| EU32 | |||||||
| EU33 | 30.49 5149.49 copies/µL | ||||||
| EU34 | |||||||
| EU35 | |||||||
| EU36 | |||||||
| EU37 | |||||||
| EU38 | |||||||
| EU39 | |||||||
| EU40 | |||||||
| EU41 | |||||||
| EU42 | |||||||
| EU43 | |||||||
| EU44 | 29.24 12,006.37 copies/µL | ||||||
| EU45 | |||||||
| EU46 | |||||||
| EU47 | |||||||
| EU48 | |||||||
| EU49 | 29.00 14,125.37 copies/µL | ||||||
| EU50 | |||||||
| EU51 | |||||||
| EU52 | |||||||
| EU53 | |||||||
| EU54 | |||||||
| EU55 | |||||||
| EU56 | |||||||
| EU57 | |||||||
| EU58 | |||||||
| EU59 | |||||||
| EU60 | |||||||
| EU61 | |||||||
| EU62 | 26.97 55,854.58 copies/µL | 27.09 51,494.95 copies/µL | |||||
| EU63 | |||||||
| EU64 | |||||||
| EU65 | |||||||
| EU66 | |||||||
| EU67 | |||||||
| EU68 | |||||||
| EU69 | |||||||
| EU70 | |||||||
| EU71 | |||||||
| EU72 | |||||||
| EU73 | |||||||
| EU74 | |||||||
| C. radicalis Isolate | Type | Type Binary | Colour (0 Pink, 1 Intermediate, 2 White) | Growth Area (mm2) | Sporulation Rate (Conidia/µL) | Cycle Threshold (Ct) Value | CHV1 Virus Concentration (Copies/µL) |
|---|---|---|---|---|---|---|---|
| ABB154 | Non-infected control | 0 | 0 | 6361.72 | 710,000 | - * | 0 |
| Infected centre | 1 | 2 | 4295.63 | 4,600,000 | 24.49 | 299,550.87 | |
| Infected edge | 2 | 2 | 2081.45 | 660,000 | 23.79 | 481,230.27 | |
| LES358 | Non-infected control | 0 | 0 | 4896.84 | 1,600,000 | - | 0 |
| Infected centre | 1 | 2 | 4464.90 | 2,650,000 | 23.21 | 712,756.48 | |
| Infected edge | 2 | 1 | 3820.38 | 1,450,000 | 23.16 | 737,304.79 | |
| LES362 | Non-infected control | 0 | 0 | 6361.72 | 1,150,000 | - | 0 |
| Infected centre | 1 | 2 | 2818.38 | 900,000 | 22.72 | 993,250.57 | |
| Infected edge | 2 | 2 | 2891.29 | 3,500,000 | 22.72 | 993,250.57 | |
| FRA135 | Non-infected control | 0 | 0 | 5202.92 | 1,820,000 | - | 0 |
| Infected centre | 1 | 1 | 3320.24 | 1,650,000 | 25.36 | 166,183.62 | |
| Infected edge | 2 | 1 | 2104.34 | 2,550,000 | 16.71 | 58,170,913.29 | |
| BOS157 | Non-infected control | 0 | 0 | 6361.72 | 1,220,000 | - | 0 |
| Infected centre | 1 | 1 | 4247.15 | 500,000 | 23.71 | 508,021.80 | |
| Infected edge | 2 | 2 | 2514.20 | 2,950,000 | 22.77 | 960,180.63 | |
| BOS158 | Non-infected control | 0 | 0 | 6361.72 | 1,220,000 | - | 0 |
| Infected centre | 1 | 1 | 3313.50 | 4,600,000 | 23.26 | 689,025.49 | |
| Infected edge | 2 | 1 | 2320.32 | 2,300,000 | 23.68 | 518,448.81 | |
| BHE156 | Non-infected control | 0 | 0 | 6361.72 | 2,300,000 | - | 0 |
| Infected centre | 1 | 1 | 3295.20 | 3,050,000 | 23.99 | 420,270.98 | |
| Infected edge | 2 | 1 | 2174.22 | 1,850,000 | 23.79 | 481,230.27 | |
| Pearson coefficient ** | −0.830 | −0.855 | 0.843 | 0.374 | N/A | −0.049 | |
| p | 0.0001 | 0.0001 | 0.0001 | 0.095 | N/A | 0.833 |
| Infected C. radicalis Isolate | ||||||||
|---|---|---|---|---|---|---|---|---|
| Single Spore Culture | ABB154 | LES358 | LES362 | FRA135 | BOS157 | BOS158 | BHE156 | Mean |
| 1 | 22.77 960,180.63 * | 13.86 400,812,425.40 | 23.07 783,641.89 | 13.26 601,743,994.60 | - 0 | 24.43 311,973.45 | - 0 | |
| 2 | 23.90 446,683.59 | 23.67 521,971.82 | 25.43 158,489.31 | - 0 | 23.27 684,374.97 | 24.35 399,341.95 | - 0 | |
| 3 | - - | 25.75 127,609.30 | 17.09 44,971,893.81 | 27.92 29,352.63 | 28.28 23,001.95 | 27.71 33,838.55 | 26.35 84,998.59 | |
| 4 | 27.29 44,971.89 | 24.54 289,577.42 | 12.80 821,685,990.30 | 26.95 56,616.25 | 30.60 4779.82 | - 0 | - 0 | |
| 5 | 24.00 416,023.29 | 22.91 873,326.16 | 7.36 32,711,908,470.00 | 6.00 82,168,599,030.00 | - 0 | 25.38 163,947.90 | 33.16 844.24 | |
| % vertical transmission | 80 | 100 | 100 | 80 | 60 | 80 | 40 | 77.14 |
| Mean positives | 24.49 299,550.87 | 22.14 1471,116.47 | 17.15 43,181,141.39 | 18.53 16,959,450.03 | 27.37 42,600.21 | 25.46 155,301.79 | 29.75 8499.85 | 23.55 566,162.59 |
Disclaimer/Publisher’s Note: The statements, opinions and data contained in all publications are solely those of the individual author(s) and contributor(s) and not of MDPI and/or the editor(s). MDPI and/or the editor(s) disclaim responsibility for any injury to people or property resulting from any ideas, methods, instructions or products referred to in the content. |
© 2024 by the authors. Licensee MDPI, Basel, Switzerland. This article is an open access article distributed under the terms and conditions of the Creative Commons Attribution (CC BY) license (https://creativecommons.org/licenses/by/4.0/).
Share and Cite
Romon-Ochoa, P.; Samal, P.; Kranjec Orlović, J.; Lewis, A.; Gorton, C.; Pérez-Sierra, A.; Biddle, M.; Ward, L. Transmission of Cryphonectria Hypovirus 1 (CHV1) to Cryphonectria radicalis and In Vitro and In Vivo Testing of Its Potential for Use as Biocontrol Against C. parasitica. Int. J. Mol. Sci. 2024, 25, 12023. https://doi.org/10.3390/ijms252212023
Romon-Ochoa P, Samal P, Kranjec Orlović J, Lewis A, Gorton C, Pérez-Sierra A, Biddle M, Ward L. Transmission of Cryphonectria Hypovirus 1 (CHV1) to Cryphonectria radicalis and In Vitro and In Vivo Testing of Its Potential for Use as Biocontrol Against C. parasitica. International Journal of Molecular Sciences. 2024; 25(22):12023. https://doi.org/10.3390/ijms252212023
Chicago/Turabian StyleRomon-Ochoa, Pedro, Pankajini Samal, Jelena Kranjec Orlović, Alex Lewis, Caroline Gorton, Ana Pérez-Sierra, Mick Biddle, and Lisa Ward. 2024. "Transmission of Cryphonectria Hypovirus 1 (CHV1) to Cryphonectria radicalis and In Vitro and In Vivo Testing of Its Potential for Use as Biocontrol Against C. parasitica" International Journal of Molecular Sciences 25, no. 22: 12023. https://doi.org/10.3390/ijms252212023
APA StyleRomon-Ochoa, P., Samal, P., Kranjec Orlović, J., Lewis, A., Gorton, C., Pérez-Sierra, A., Biddle, M., & Ward, L. (2024). Transmission of Cryphonectria Hypovirus 1 (CHV1) to Cryphonectria radicalis and In Vitro and In Vivo Testing of Its Potential for Use as Biocontrol Against C. parasitica. International Journal of Molecular Sciences, 25(22), 12023. https://doi.org/10.3390/ijms252212023

